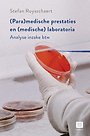

Prof. dr. Ed Nozeman is zelfstandig gevestigd consultant in Amersfoort, bijzonder hoogleraar Vastgoedontwikkeling aan de Rijksuniversiteit Groningen en gasthoogleraar Vastgoedontwikkeling aan de Amsterdam School of Real Estate.
Meer over de auteursHandboek Projectontwikkeling, studenteneditie
Samenvatting
Projectontwikkeling is een veelzijdig vak in een dynamische omgeving. De ruimte waarin wij leven is door mensenhanden gemaakt en in het proces spelen projectontwikkelaars een belangrijke rol. De taak voor het realiseren van een kwalitatief hoogwaardig gebouwde omgeving waarin het goed wonen, werken, winkelen en verblijven is, vraagt een brede kennis, een scherp inzicht in private en publieke wensen en bovenal vakmanschap.
Het Handboek Projectontwikkeling beschrijft het volledige projectontwikkelingsproces. Van de initiatieffase tot en met de exploitatie van onroerend goed wordt helder uiteengezet welke activiteiten door welke spelers worden ontplooid, welke wet- en regelgeving van toepassing is, welke werkvormen bestaan en hoe verantwoordelijkheden zijn of kunnen worden verdeeld.
Voor studenten aan vastgoed gerelateerde opleidingen en professionals in de vastgoedsector levert dit boek een breed scala aan kennis en inzichten. Een handig studieboek en naslagwerk voor iedereen die werkt aan gebied- en locatie-ontwikkelingen en die meer wil weten over de totstandkoming en exploitatie van onroerend goed.
De auteurs zijn allen erkende deskundigen in hun discipline binnen de projectontwikkeling. De NEPROM heeft hun kennis en ervaring tot dit standaardwerk gebundeld.
Specificaties
Vaak samen gekocht
Anderen die dit boek kochten, kochten ook
Net verschenen
Rubrieken
- aanbestedingsrecht
- aansprakelijkheids- en verzekeringsrecht
- accountancy
- algemeen juridisch
- arbeidsrecht
- bank- en effectenrecht
- bestuursrecht
- bouwrecht
- burgerlijk recht en procesrecht
- europees-internationaal recht
- fiscaal recht
- gezondheidsrecht
- insolventierecht
- intellectuele eigendom en ict-recht
- management
- mens en maatschappij
- milieu- en omgevingsrecht
- notarieel recht
- ondernemingsrecht
- pensioenrecht
- personen- en familierecht
- sociale zekerheidsrecht
- staatsrecht
- strafrecht en criminologie
- vastgoed- en huurrecht
- vreemdelingenrecht